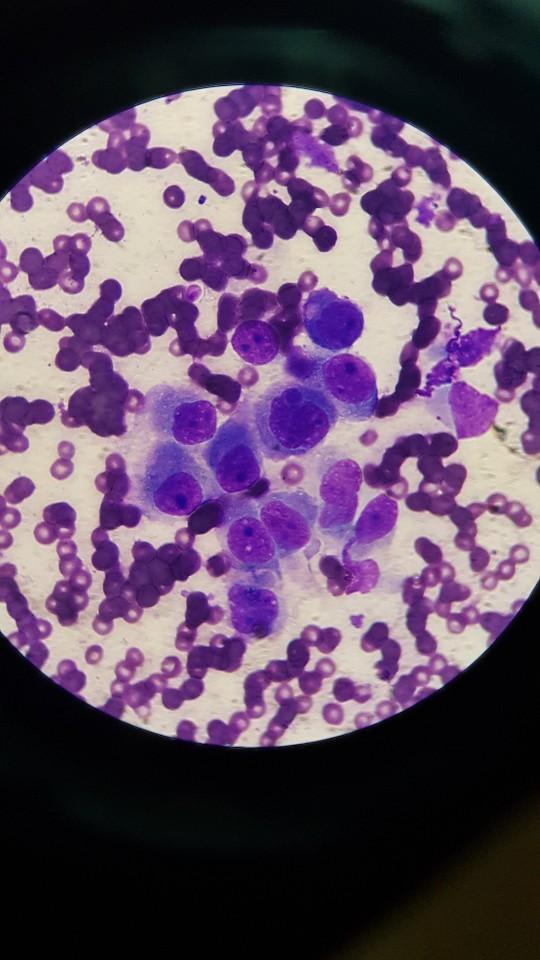
Question details sensitive content

My senior dog has bone cancer. Is the diagnosis accurate? What are options?
Updated On September 23rd, 2025
Pet's info: Dog | DOG-LARGE-LONGHAIR | Female | spayed | 11 years and 11 months old | 56 lbs
My 12 year dog was diagnosed as bone cancer after x-ray and fine-needle biopsy. I'm devastated since my dog has very poor hip (she received bilateral triple pelvic osteotomy and suffered from severe arthritis in her hips every since. Her hind legs have almost no muscle left) so I don't think I'll let her go through amputation. I'm attaching two images. Would you let me know if there is 0 likelihood of wrong diagnosis?

1 Answer
Most Helpful Answer
Published on March 22nd, 2019
A bone aspirate is pretty definitive for diagnosing osteosarcoma, and I would trust a pathologist's reading of the images that you posted. I also think the radiograph looks consistent with a primary bone tumor, and the location is typical as well. If you are still interested in some treatment palliative radiation might be an option that could bring some comfort for a period of time without amputation. Ask your vet about palliative options.
1Pet Parents found this answer helpful

Book an appointment with the pros – our expert vets are here to help.


